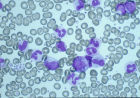
慢性白血病
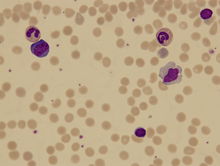
異型淋巴細胞

概述
 慢性白血病
慢性白血病男性發病率高於女性。 慢性淋巴細胞白血病,簡稱慢淋(chronic lymphocytic leukemia,CLL),是機體的淋巴細胞在體內異常增生和積蓄伴有免疫功能低下的疾病。在我國CLL發病率低,一般只占白血病發病總數的10%以下,居白血病類型的第4位。由於慢淋患者淋巴細胞壽命極長,並經常伴有免疫反應缺陷,故又稱“免疫無能淋巴細胞蓄積病”。
病因
中醫
①七情內傷,情志不調,致氣機不暢,肝氣鬱結,氣鬱日久,則氣滯血瘀,脈絡壅聚, 瘀血內停,久積成塊。
②飲食失調,過食肥甘酒食,傷及脾胃,脾虛失運,輸布津液無權,濕濁內生,凝聚成積,痰氣相搏,血流不暢,瘀塊內生。
③起成無常,寒溫不調,感受外邪。
西醫
(一) 慢性粒細胞白血病的發病機理
(1) 細胞遺傳學
(2) G-6-PD同工酶
(3) 細胞動力學
慢性白血病
慢性白血病細胞,而且還是白血病細胞的“倉庫”和“隱蔽所”,並為其增殖轉移提供了一個有利的環境,且使白血病細胞在骨髓、血液與脾臟間的往返循環增加,使細胞正常的釋放調節過程受到破壞。
(二) 慢性淋巴細胞白血病的發病機理
(1) 染色體異常
(2) 白血病的克隆發生
(3) 細胞動力學異常
慢粒白血病的診斷
慢粒白血病屬於中醫“虛勞”、“積聚”、“血證”的範疇,主要是根據其臨床體徵和舌脈決定的。中醫分型為:熱毒熾盛型、氣滯血瘀型、正虛瘀結型。
1、正虛瘀結:白血病患者積塊堅硬,疼痛不移,神疲倦怠,不思飲食,消瘦脫形,面色萎黃,自汗盜汗,肌膚甲錯,頭暈心慌,唇甲少華,舌淡或暗,脈弦細或沉細。
2、熱毒熾盛:壯熱持續,汗出不解,煩躁不安,甚則譫語神昏,口燥而不甚渴,肋下腫塊繼增, 硬痛不移,白血病患者倦怠乏力,形體消瘦,面色晦暗,骨節劇痛,或衄血不止,舌紅無苔,脈細數。
3、氣滯血瘀:腔腹脹滿、肋下有塊,軟而不堅,固定不移,苔薄脈弦。
分型
慢性白血病,分為慢性髓細胞性白血病和慢性淋巴細胞白血病。
臨床表現
臨床表現
 慢性髓性白血病靶向藥物,格列衛
慢性髓性白血病靶向藥物,格列衛病人多系老年人,起病十分緩慢,往往無自覺症狀,偶因實驗室檢查而確診。
(1)症狀:早期可有倦怠乏力、逐漸出現頭暈,心悸氣短,消瘦,低熱,盜汗,皮膚紫癜,皮膚瘙癢,骨骼痛,常易感染,約10%病人可並發自身免疫性溶血性貧血。
(2)體徵:
 慢性白血病
慢性白血病①淋巴結腫大,以頸部淋巴結腫大最常見,其次是腋窩、腹股溝和滑車淋巴結腫大,一般呈中等硬度,表面光滑,無壓痛,表皮無紅腫,無粘連。如縱隔淋巴結腫大,壓迫支氣管引起咳嗽,聲音嘶啞或呼吸因難。CT掃描可發現腹膜後,腸系膜淋巴結腫大。
②肝脾腫大:肝臟輕度腫大,脾腫大約占72%,一般在肋下3~4crn,個別患者可平臍,腫大呈度不及慢性粒細胞白血病明顯。
③皮膚損害:可出現皮膚增厚,結節,以致於全身性紅皮病等。
臨床主要表現是以淋巴結腫大為主,常伴有肝脾腫大,貧血及出血等症狀,少數患者還伴有皮膚損害。本病中老年人居多,偶見青年,男性多於女性。
根據慢性白血病的臨床淋巴結腫大,肝脾腫大及乏力等特徵,屬中醫“症瘕”、“積聚”、“瘰癧”、“虛勞“等範疇。
實驗室檢查
異型淋巴細胞
異型淋巴細胞(1)血象:白細胞總數常>15×109/L,一般在30×109/L~200×109/L,
分類中約80%~90%為成熟小淋巴細胞,有少量異型淋巴細胞和幼淋巴細胞,血片上易見破碎細胞,隨著病情發展可出現血紅蛋白和血小板計數降低。貧血為正細胞、正色素性貧血,溶血時,網織紅細胞升高。
(2)骨髓象:顯示增生明顯活躍,淋巴系占優勢,成熟小淋巴細胞占50%~90%,偶見原始和幼稚淋巴細胞,晚期可見紅、粒、巨三系細胞明顯減少。有溶血時,紅系細胞可見代償性增生。
(3)免疫學檢查:細胞表面標誌具有單克隆性,細胞具有慢性淋巴細胞白血病的免疫學特點(Sig、CD5、C3d、CD19、CD20、CD4,鼠紅細胞玫瑰花瓣受體為陽性),個別病人血中可見單克隆免疫球蛋白。溶血時可見抗人球蛋白試驗陽性。
 慢性白血病
慢性白血病(4)細胞遺傳學:約半數的慢性淋巴細胞白血病出現染色體異常,最常見的數目異常為增加
一個12號染色體(+12),其次可見超數的3號,16號,或18號染色體。常見的結構異常為12和11號染色體長臂相互易位,6號染色體短臂或長臂的缺失,11號染色體長臂的缺失,14號染色體長臂的增加等染色體的改變。有報導,具有“+12”的慢性淋巴細胞白血病患者,從診斷到出現有治療指征的臨床症狀的時期明顯短於無“+12”的對照組,故認為“+12”似乎和短促的病程及不良的預後有關。
(5)生化和組化:淋巴細胞PAS反應強陽性,約1/3病人Coomb’s試驗陽性。部分病人有低丙種球蛋白血症,植物血凝素(PHA)轉化率明顯降低。
慢性淋巴細胞急變
 慢性白血病
慢性白血病慢性淋巴細胞急性變極少見,發生急變的時間可1~20年不等。可發生急性淋巴細胞白血病,急性粒細胞白血病,急性單核細胞白血病,幹細胞白血病,急性漿細胞白血病和紅白血病等。一旦發生急變,常迅速死亡。
診斷標準
(1)臨床表現:
①可有疲乏,體力下降,消瘦、低熱,貧血或出血表現。
②可有淋巴結(包括頭頸部,腋窩,腹股溝)、肝、脾腫大。
(2)實驗室檢查:
①外周血WBC>10×109/L,淋巴細胞比例≥50%,絕對值≥5×109/L,形態以成熟淋巴細胞為主,可見幼稚淋巴細胞或不典型淋巴細胞。
②骨髓象:骨髓增生活躍或明顯活躍,淋巴細胞≥40%,以成熟淋巴細胞為主。
(3)免疫分型:
①B-CLL:小鼠玫瑰花結試驗陽性:SIg弱陽性,呈K或λ單克隆輕鏈型;CD5,CD19、CD20陽性;CD10、CD22陰性。
②T—CLL:綿羊玫瑰花結試驗陽性:CD2、CD3、CD8(或CD4)陽性,CD5陰性。
(4)形態學分型:B—CLL分為3種亞型:
①典型CLL:90%以上為類似成熟的小淋巴細胞。
②CLL伴有幼淋巴細胞增多(CLL/PL):幼稚淋巴細胞>10%,但<50%。
 淋巴細胞
淋巴細胞T-CLL細胞形態分為以下4種:
①大淋巴細胞型:細胞體積較大,胞漿為淡藍色,內有細或粗的嗜天青顆粒,胞核圓形或卵圓形,常偏向一側,染色質聚集成塊,核仁罕見。
②幼稚T細胞型:胞核嗜鹼性增強,無顆粒,核仁明顯。
③呈腦回樣細胞核的小或大淋巴細胞。
④細胞形態多樣,胞核多有分葉。
(5)臨床分期標準:
①I期:淋巴細胞增多,可伴有淋巴結腫大。
②Ⅱ期:Ⅰ期加肝或脾大、血小板減少<100×109/L。
③Ⅲ期:Ⅰ期或Ⅱ期加貧血(Hb<100g/L)。
除外淋巴瘤合併白血病和幼淋巴細胞白血病,外周血淋巴細胞持續增高≥3個月,並可排除病毒感染、結核、傷寒、傳染性單核細胞增多症等引起淋巴細胞增多的疾病,應高度懷疑本病。在較長期連續觀察下,淋巴細胞仍無下降,結合臨床、血象、骨髓象和免疫表型,可診斷為本病。
鑑別診斷
就淋巴結腫大,白細胞增多和肝脾腫大的特徵,臨床上需要與下列疾病相鑑別。
(1)慢性粒細胞白血病:白細胞升高明顯(100×109~500×109/L),骨髓中以中晚幼粒細胞增生為主,中性粒細胞鹼性磷酸酶減少或消失,有Ph’染色體陽性,脾腫大顯著。 (2)慢性單核細胞白血病:白細胞計數輕、中度增高,肝、脾、淋巴結腫大不顯著,血象和骨髓象以成熟單核細胞為主,偶見幼單核細胞。
(3)淋巴瘤:淋巴結呈進行性的無痛性腫大,深部淋巴結腫大可壓迫鄰近器官,血象無特殊變化,骨髓塗片和活檢找到Reed—sternbery細胞或淋巴瘤細胞。淋巴結活檢可見:正常濾泡性結構為大量異常淋巴細胞或組織細胞所破壞;被膜周圍組織同樣有異常淋巴細胞或組織細胞浸潤;被膜及被膜下竇也被破壞。
(4)淋巴結結核:常為頸部局限性淋巴結腫大,淋巴結質地較軟,有壓痛及粘連,甚至壞死或破潰。淋巴結活檢:有結核桿菌或乾酪樣壞死。抗結核治療有效。
(5) 病毒感染:淋巴細胞增多為多克隆性的,增多是暫時性的,隨著感染的控制,淋巴細胞數量恢復正常。
常規治療
慢粒臨床可分慢性期、加速期、急變期三個階段,各階段臨床表現各有不同,慢性期治療可以中藥為主,配合化療藥治療,加速期和急變期應以化療為主,配合中藥治療。
西醫治療
(一) 慢性粒細胞白血病
療效標準
對CML治療效果的判定可分為在血液形態學、細胞遺傳學及分子生物學等不同水同上的評價。CML血液學緩解的標準為:臨床無貧血、出血、感染及白細胞浸潤表現;血象:血紅細胞高於100g/L,白細胞數低於10×109/L,分類無不成熟細胞,血小板在(100~400)×109/L;骨髓象正常。CML細胞遺傳學緩解的標準是標誌CML克隆的ph1染色體的消失。
單一化療藥物治療
單一藥物治療CML可套用的藥物包括達沙替尼如:施達賽,一種第二代酪氨酸激酶抑制劑,ML慢性期患者推薦起始劑量為100mg, QD,口服。早晚均可。Ph+CML加速期、急變期患者推薦起始劑量為140mg QD, 口服,早晚均可。治療持續時間:在臨床試驗中,本品治療均持續至疾病進展或患者不再耐受該治療。 烷化劑如:馬里蘭、馬法蘭、苯丁酸氮芥、二溴甘露醇等、抗代謝藥如羥基脲、6-巰基嘌呤(6-MP)、6-硫鳥漂呤(6-TG)等,高三尖杉酯鹼以及中國醫學科學院血液學研究和套用的中藥靛玉紅和異靛甲等。
聯合化療
受急性白血病治療中聯合化療於單藥治療的啟示,對於CML人們近年來也嘗試了採用聯合化療的治療方法。
干擾素
干擾素(IFN)具有抗病毒、抑制細胞增殖、誘導分化、免疫調節等IFN 可分為α、β、γ三大類,IFN-α和IFN-β對酸穩定,具有相同的受體,均由白細胞和成纖維細胞產生。
骨髓移植及外周血造血幹細胞移植
(1) 自體骨髓移植(ABMT)或自體外周血造血幹細胞移植(APBCT):ABMT和APBSCT治療CML的目的主要是延長慢性期或使晚期病人重新回到慢性期,從而延長病人的生存期。
(2) 同基因骨髓移植:此種BMT是對CML病進行BMT治療和最早嘗試。
(3) 同種異基因骨髓移植:同種異基因骨髓移植(ALLo-BMT)幾乎是目前能夠徹底治癒CML的惟一手段,也是CML治療的最佳方法。
(4)加速期和急變期的治療: CML 一旦進入加速期病期病情多不穩定,約有2/3的病人會繼而發生急變。此階段已為CML的晚期,治療比較困難。
預後與轉歸
 骨髓纖維化
骨髓纖維化目前認為年齡小於40歲,脾腫大不明顯,外周血中血小板較低,原始細胞百分比不高,CR小於1年以及BMT前時間短均為CML的有利因素。CML最終可合併骨髓纖維化、急性白血病及
多臟器衰竭,並發感染,出血等嚴重併發症而死亡。 慢淋病程懸殊不一,短至1~2年,長至5~10年,甚至20年。病程長短與病情緩急、全身病狀、肝脾腫大、血象和骨髓象變化等有關。一般年齡偏大,預後為好,就診前無症狀期,生存期長,反之預後較差,常見死亡原因為感染 ,尤以肺部感染多見。慢性急變而死亡較罕見。
治療措施
治療原則
對於慢粒的治療不必操之過急,白細胞計數在100×109/L以下的患者不需立刻治療、因為循環中主要是成熟的粒細胞,其體積較原始細胞小且具有較好的變形能力,白細胞計數在200×109/L以上者需採取積極治療措施。當前以採用細胞毒藥物作化療為主。對於那些因白細胞極度增生而出現的症狀,如有陰莖異常勃起、呼吸窘迫、視力模糊、心理變態等,則應在進行急性的白細胞除去術的基礎上聯用骨髓抑制劑進行治療。
化學治療
 絲裂黴素
絲裂黴素此藥之優點。用法為2mg每日3次,一直用至白細胞降至14×109/L以下停用或間歇給藥。一般規律是用藥1-2周自覺症狀好轉,4~6周明顯好轉。當白細胞減至10×109/L時,減量至1-2mg/d,一直維持2-3個月。停藥後,如白細胞波動在10~50×109/L間,可考慮小劑量維持1年以上。白細胞減少到5~10×109/L血小板在100×109/L以下,或者有慢粒急變傾向才應停藥。馬里蘭的毒副作用主要是骨髓抑制,特別是血小板減少。個別病人雖用藥量不大也會出現全血細胞減少,恢復較慢。長期服用此藥可引起肺纖維化,皮膚色素沉著。類似慢性腎上腺皮質功能減退的症狀,精液缺乏或停經。HU開始劑量為每日3g,口服。用後白細胞數下降很快。當降至20×109/L左右時,將劑量減至一半;降至10×109/L時,將劑量再減少。維持劑量約每日0.5-1.0g。一般不完全停藥,因停藥後白細胞計數很快上升。此藥優點是作用快;如果白細胞下降過多,停藥後能很快上升;副作用少。缺點是需經常驗血以指導治療。另外,亦可聯合α-IFN(α-干擾素)治療慢粒。方法,口服HU2.0-6.0g/d,同時皮下注射。α-IFV300萬u,iv,每周3次,套用8~32周。當白細胞降至10×109/L,HU減少繼續用1-2周,根據情況停用或用小劑量。HU維持量為0.5-1.0/d,有條件者可繼續用。α-IFN300萬u,iv,每周一次。用藥期間每周查血常規2次,骨髓象每4周檢查一次。
放射治療
深部x線,用深部x線對全身和局部的肝脾區以及浸潤部位照射。脾區照射開始劑量為50cGy,以後每日或隔日100~200cGy。白細胞降至20×109/L時停止。對化療效果不佳或復發的可以用放療,據報導,其療效不低於BUS。核素32P治療,僅用於對BUS及脾區放療效果不佳者。32P劑量是根據白細胞增多程度而定,若白細胞總數>50×109/L,32P的開始劑量為1-2.5mCi,靜注。2周后再用1-1.5mCi,以後每隔2周給同樣劑量1次,待白細胞降至20×109/L時停用。在緩解期間,每1-3個月觀察1次,當白細胞>25×l09/L時,可再給1-1.5mCi。
脾切除術
脾臟可能是慢粒急變的首發部位,切除脾臟可能延緩急變和延長患者存活期。切除脾臟的手術指征:
① 確診為慢粒者;
② 對化療反應良好;
③ 65歲以下且無大手術禁忌症者。慢粒急變是手術的禁忌症。
骨髓移植
年齡在45-50歲在慢性期的病人,以親兄弟姐妹HLA相同的異基因骨髓作移植。移植成功者,一般能獲得長期的生存或治癒。
其他治療
化療前如果白細胞數在500×109/L以上,可先用血細胞分離機作白細胞除去術以迅速降低白細胞數,避免白細胞過多可能阻塞微血管而引起的腦血管意外的危險。化療開始時,特別是用Hu治療時,宜同時加用別嘌呤醇0.1g每日3次,以防止細胞破壞過多過速而引起尿酸腎症。
慢粒急變的治療
慢粒急變的治療比急性白血病的治療困難,完全緩解僅10.7%,目前慢粒急變的治療方案如下:Ara-c(環阿糖胞苷)100mg/m2·d,第1-14天;ADM(阿黴素)30mg/m2·d,第1-3天;VCR2mg,第1天;上述藥物相繼靜脈輸注。PDN40mg/m2·d,分次口服,第l-7天。
對生育的影響
慢性白血病是一類進展較為緩慢的白血病,但不影響患者的生育功能。
患者在患病期間會存在抵抗力下降、貧血、有出血傾向等等問題,只是較急性白血病來說這些症狀輕微一些;另外慢性白血病的最佳治療期是在慢性期,因此在慢性白血病患者未康復前不建議懷孕:
首先,患者抵抗力較差,在妊娠期間容易發生感染。
其次,患者凝血功能較差,在分娩期容易發生大出血危及生命 。
然後,治療的藥物對人體細胞有致畸作用,在治療期妊娠容易導致流產或胎兒畸形。
最後,白血病細胞會侵潤人體各個器官,在患病期間懷孕,胎兒可能會死亡。病人在獲得治癒後(完全緩解5年內未復發),也不應該立刻考慮生育,而應該再等1-2年,以便身體內殘餘的化療藥物逐漸通過代謝排除,以降低胎兒畸形發生率。
慢性白血病儘管進展緩慢,但是總體來說白血病都是一類很兇險的畸形,最佳治療期在慢性期,如果不積極對待,到了加速期和急變期治癒的可能性就很小了。
飲食要求
慢性白血病患者在治療和康復上十分重要,建議慢性白血病患者在飲食上做到以下要求:
1.宜供給低脂肪、高蛋白、富含維生素等營養豐富的軟食。不宜食煎炸、堅硬、鋒利的食物,忌食菸酒,以免刺激或導致口腔潰瘍。
2.病人口腔有潰瘍、出血時,應給以溫熱的半流或全流汁狀飲食,可少食多餐,忌燙食。
3.病人感腹痛時可暫禁食,以觀察腹痛變化情況。如出現噁心、嘔吐、便血時,也要禁食,便血停止24小時後再給少量較稀的食物。
4.對輸血多的慢性白血病人,要注意血液檢驗的結果,血中鐵含量高的病人不宜食含鐵豐富的食物,也不要用鐵鍋做飯菜。
5.長期使用激素治療的病人,容易發生骨質疏鬆和應激性消化道潰瘍,故要每天堅持飲鮮牛奶,適當吃點新鮮蔬菜、水果。
急慢性白血病的區分
概述
急慢性白血病的區分除發病的急緩外,還主要依據:
(1)預期壽命或自然進程未經治療的急性白血病患者的預期壽命平均不到1年,而慢性白血病的預期壽命則平均為1-3年;
(2)白血病細胞的分化、成熟程度急性白血病骨髓或外周血中主要的白血病細胞為原始(淋巴系、粒系或單核系)細胞,而慢性白血病的骨髓和外周血中主要是成熟的和幼稚階段的粒細胞(慢性粒細胞白血病)或成熟的小淋巴細胞(慢性淋巴細胞白血病)。
白血病辯證食療方
石家莊智魁中醫血液病醫院針對最近一段時期以來,接觸到很多白血病患者夏天不知道如何增進食慾,食慾下降導致病情反覆,因此特辨證推出了幾款特色食療方,希望能夠對廣大白血病患者有所幫助。(建議在醫囑情況下,合理利用。請勿亂用,以免出現不必要的麻煩。)
一、溫熱瘀體型白血病
【臨床表現】 壯熱、鼻衄、牙宣、黏膜皮膚瘀點瘀斑,心煩便秘,口乾,舌質絳紅少津,苔黃燥,脈弦滑數。
【食療藥膳】
1、草莓檸檬汁:草莓90克,蜂蜜50毫升,檸檬汁90毫升,西瓜汁60毫升。將草莓絞取汁液和其他原料混合調勻,加些冰塊,即可飲服。每日2-3次。
2、蘆薈飲:蘆薈葉1片(約30厘米長),白糖25克,蘋果1個,梨1個。將蘆薈、蘋果、梨用壓榨機壓榨出汁,汁液加糖調和,即可飲用。每日2次。
3、生地紫草茜草根粥:生地30克,紫草15克,茜草根15克,粳米60克。將生地、紫草、茜草根加水500毫升,煎熬成300毫升,藥汁,加入適量清水和粳米煮粥食用。
二、氣陰兩虛型白血病
【臨床表現】 心悸氣短、低熱盜汗、頭暈耳鳴、口咽乾燥,睡眠不寧,舌淡紅,少苔,脈沉數。
【食療藥膳】
1、海參天冬粥:海參100克,天冬25克,粳米100克,冰糖少許。將海參切片;天冬切斜條煎取濃汁,去渣,入粳米、海參煮粥,煮沸加入冰糖適量,至粥熟食用,每日1-2次。
2、沙參玉竹蟲草燉龜肉:沙參、玉竹各15克,冬蟲草5克,龜肉100克,同放入燉盅文火隔水燉3小時,調味飲湯食肉。
慢性粒細胞白血病簡介
 玉竹蟲草燉龜肉
玉竹蟲草燉龜肉慢性粒細胞白血病簡稱慢粒,是一種起源於多能幹細胞的腫瘤性
增生疾病,其主要特點是粒細胞顯著增多,脾臟明顯腫大,絕大多數具有相對特異的ph標記染色體,病程較緩慢,大多以急性變而死亡。
該病各年齡均可發生,但以中年最為常見。早期多無明顯症狀,偶然因發現粒細胞增多或脾腫大而被確診。患者除有低熱、消瘦及乏力症狀外,可因脾腫大壓迫胃腸而引起食慾減退、左上腹墜痛等消化道症狀。晚期病例幾乎都有脾腫大,甚至可占滿全腹而入盆腔,質地堅硬而表面光滑。脾栓塞或脾周圍炎併發症較其他白血病為多見。約40%的病人有肝腫大,約75%的病人有胸骨壓痛,但淋巴結腫大以及皮膚、眼眶及骨組織浸潤很少見,除非患者有急變傾向。當外周血白細胞>60×10'/L時可有視網膜靜脈擴張、增粗或出血,伴滲出物及結節等;當白細胞基數>200×10'/L時可發生白細胞淤滯症,可導致中樞神經系統出血、陰莖異常勃起,甚至骨髓壞死。
慢性粒細胞白血病自然病程可分為慢性期和加速期。大多數患者在慢性期可得到確診,經過一段慢性期後病程開始進入加速期,此時臨床各種症狀較為明顯。急變期是指慢性粒細胞白血病轉變為急性白血病的過程,系大多數慢粒的終末期表現。急變可發生在慢性期的任何階段,臨床表現與其他急性白血病相似。
中醫辨證及飲食禁忌
氣滯血瘀型
 海參
海參禁食滯氣傷胃的食物,如羊肉、牛肉、 狗肉等肉類,以及海參、蝦、蟹、蛇肉等腥膻之物
,皆因儘量少 食或不食,血瘀明顯則應禁食黑木耳、石榴、柿子、栗子等。不宜飲啤酒、咖啡。
痰瘀毒結型
禁忌辛溫熱類食物,如辣椒、大蔥、大蒜、蒜薹、洋蔥、芥末、花椒、胡椒、韭菜等大熱之品。一些溫熱類的水果,如龍眼、鳳梨、桃、橘、荔枝、石榴、栗子、椰子等亦當少食。服藥期間不宜飲啤酒、白酒、咖啡。
正虛瘀結型
此類患者大多體質較差,既不耐攻,又不任補。應禁服大熱大涼之品,以免再傷胃氣,後天無力而 變生危證。如辣椒、蔥、蒜、胡椒、韭菜等溫燥之品,以及生黃 瓜、生蘿+、西瓜、生荸薺等涼性果蔬均不宜食,烈酒及各種冷飲忌用。
氣血兩虛型
 性寒食物
性寒食物慢性白血病的食療藥膳
慢性白血病患者由於機體代謝亢進,需給以高熱量、高蛋白、富含維生素、礦物質而易消化的飲食,以補充體內熱量及各種營養物質的消耗。尤其是進行化療期間患者常有食欲不振、腹脹、腹瀉、噁心、嘔吐等消化道反應,應注意菜餚的色、香、味、型,以引起患者的食慾。
1、鵝血粥 :鵝血100克,粳米50克。將新鮮鵝血隔水蒸熟備用,粳米煮熟,加人鵝血、食鹽煮開飲服,常服有效。
2、粳米、豬肝、蓮子、大棗粥 :粳米50克,蓮子20克(水泡),熟豬肝(切成丁)30克,大棗10個,加水適量熬粥,早晚分服,有防治貧血的作用。
3、大棗桂圓薏米粥 :大棗10個,桂圓20克,薏米40克,加水適量熬成粥,早晚食用。大棗、桂圓、慧米均為健脾益胃滋補之品,經常食用可增強體質,提高機體抗癌免疫功能。腫瘤患者貧血、身體虛弱或因放療、化療引起血紅蛋白低下、白細胞減少及血小板減少者,均有較好輔助療效。
4、冬蟲夏草湯:選用天然蟲草素含量較高的福臨門冬蟲夏草,粉碎後服用,每次1.5克,每日2次,連續服用一個月大部分患者可取得良好的療效。研究發現冬蟲夏草對人體造血系統的主要作用是因為蟲草多糖能提高骨髓細胞的造血功能,促進紅細胞生成,同時對抗白血病和粒細胞減少。這對某些白血病人或正在接受化療的病人有很積極的作用。
5、豬蹄黃豆銀耳湯 :鮮豬蹄1隻,黃豆25克,乾銀耳10克,食鹽10克,水適量。先把豬蹄黃豆煮熟後,再加人銀耳文火同煮5~10分鐘,連湯服用。本品既能增加病人的營養,又能增強腫瘤病人對放療、化療的耐受能力。
6、鮮蘑白菜水餃
鮮蘑菇100克,麵粉、白菜各500克,調料適量。?
麵粉與微量精鹽、200克冷水相和,反覆擦搓成光滑、柔軟的麵團,加蓋醒15分鐘。白菜洗淨,入沸水中燙軟,剁碎,與鮮蘑末拌合,加薑汁、蔥花、黃酒、精鹽、麻油、味素,調製成餡,把麵團分60份,擀皮,包成餃子,入沸水中煮熟。有解毒抗癌功效。適合於白血病、子宮癌、皮癌、肉瘤等。?
7、粳米、豬肝、蓮子、大棗粥:粳米50克,蓮子20克(水泡),熟豬肝(切成丁)30克,大棗10個,加水適量熬粥,早晚分服,有防治貧血的作用。
8、薏米甲魚
甲魚(鱉)1隻(約500克),薏米50克,調料適量。甲魚宰殺後,用沸水燙過,脫去背部黑泥,在腹部開個十字形口,去內臟及爪內黃油,用酒、薑片、精鹽漬半小時,薏米浸發後,填入甲魚腹內,放入蔥、姜、鹽、味素等,上屜蒸2~2.5小時。有滋陰補虛,軟堅散結的功效。適用於陰虛潮熱,肝脾腫大等症。
白血病的護理
慢性白血病
1、增加營養,可以讓患者朋友們增強體質,補充人體內所需要的營養物質,所以注意飲食衛生是日常生活中白血病的護理方法之一。給予高蛋白、高維他命、高熱量飲食。鼓勵患兒進食。食品食具應消毒,水果應洗淨、去皮。
2、輸血的護理這也是慢性白血病患者護理的一種。由於白血病是一種血液疾病,會給人們帶來很大的傷害性,而且治療白血病最主要是靠化療進行,然而骨髓暫時再生低下是有效化療的必然結果。白血病在治療過程中往往需輸血液成份或輸血進行支持治療。輸注時應嚴格輸血制度。一般先慢速滴注觀察15分鐘,若無不良反應,再按患兒年齡、心肺功能、急慢性貧血及貧血程度調整滴速。輸血過程中應密切觀察輸血造成的不良反應。
急性白血病
1、防護感染,感染是誘發急性白血病病人死亡的主要因素之一。急性白血病病人免疫功能下降,化療藥品對骨髓控制能使成熟中性粒細胞下降或匱乏,讓免疫功能進一步降低。粒細胞缺少或匱乏也是免疫功能下降察覺感染的主要原因。粒細胞減少持續越長時間,感染的威脅愈大。預防感染可採取如下方法。
2、要注意適當安排活動量,適量的活動能輔助診療,並且急性白血病患者要臥床休息;減輕期患者可適當起床活動,若發覺心慌、氣息短應停止活動,不能下床活動的病人,可在床上活動或按摩;協助重症病人洗漱、進餐、大小便、翻身等,以減少病人體力消耗。

